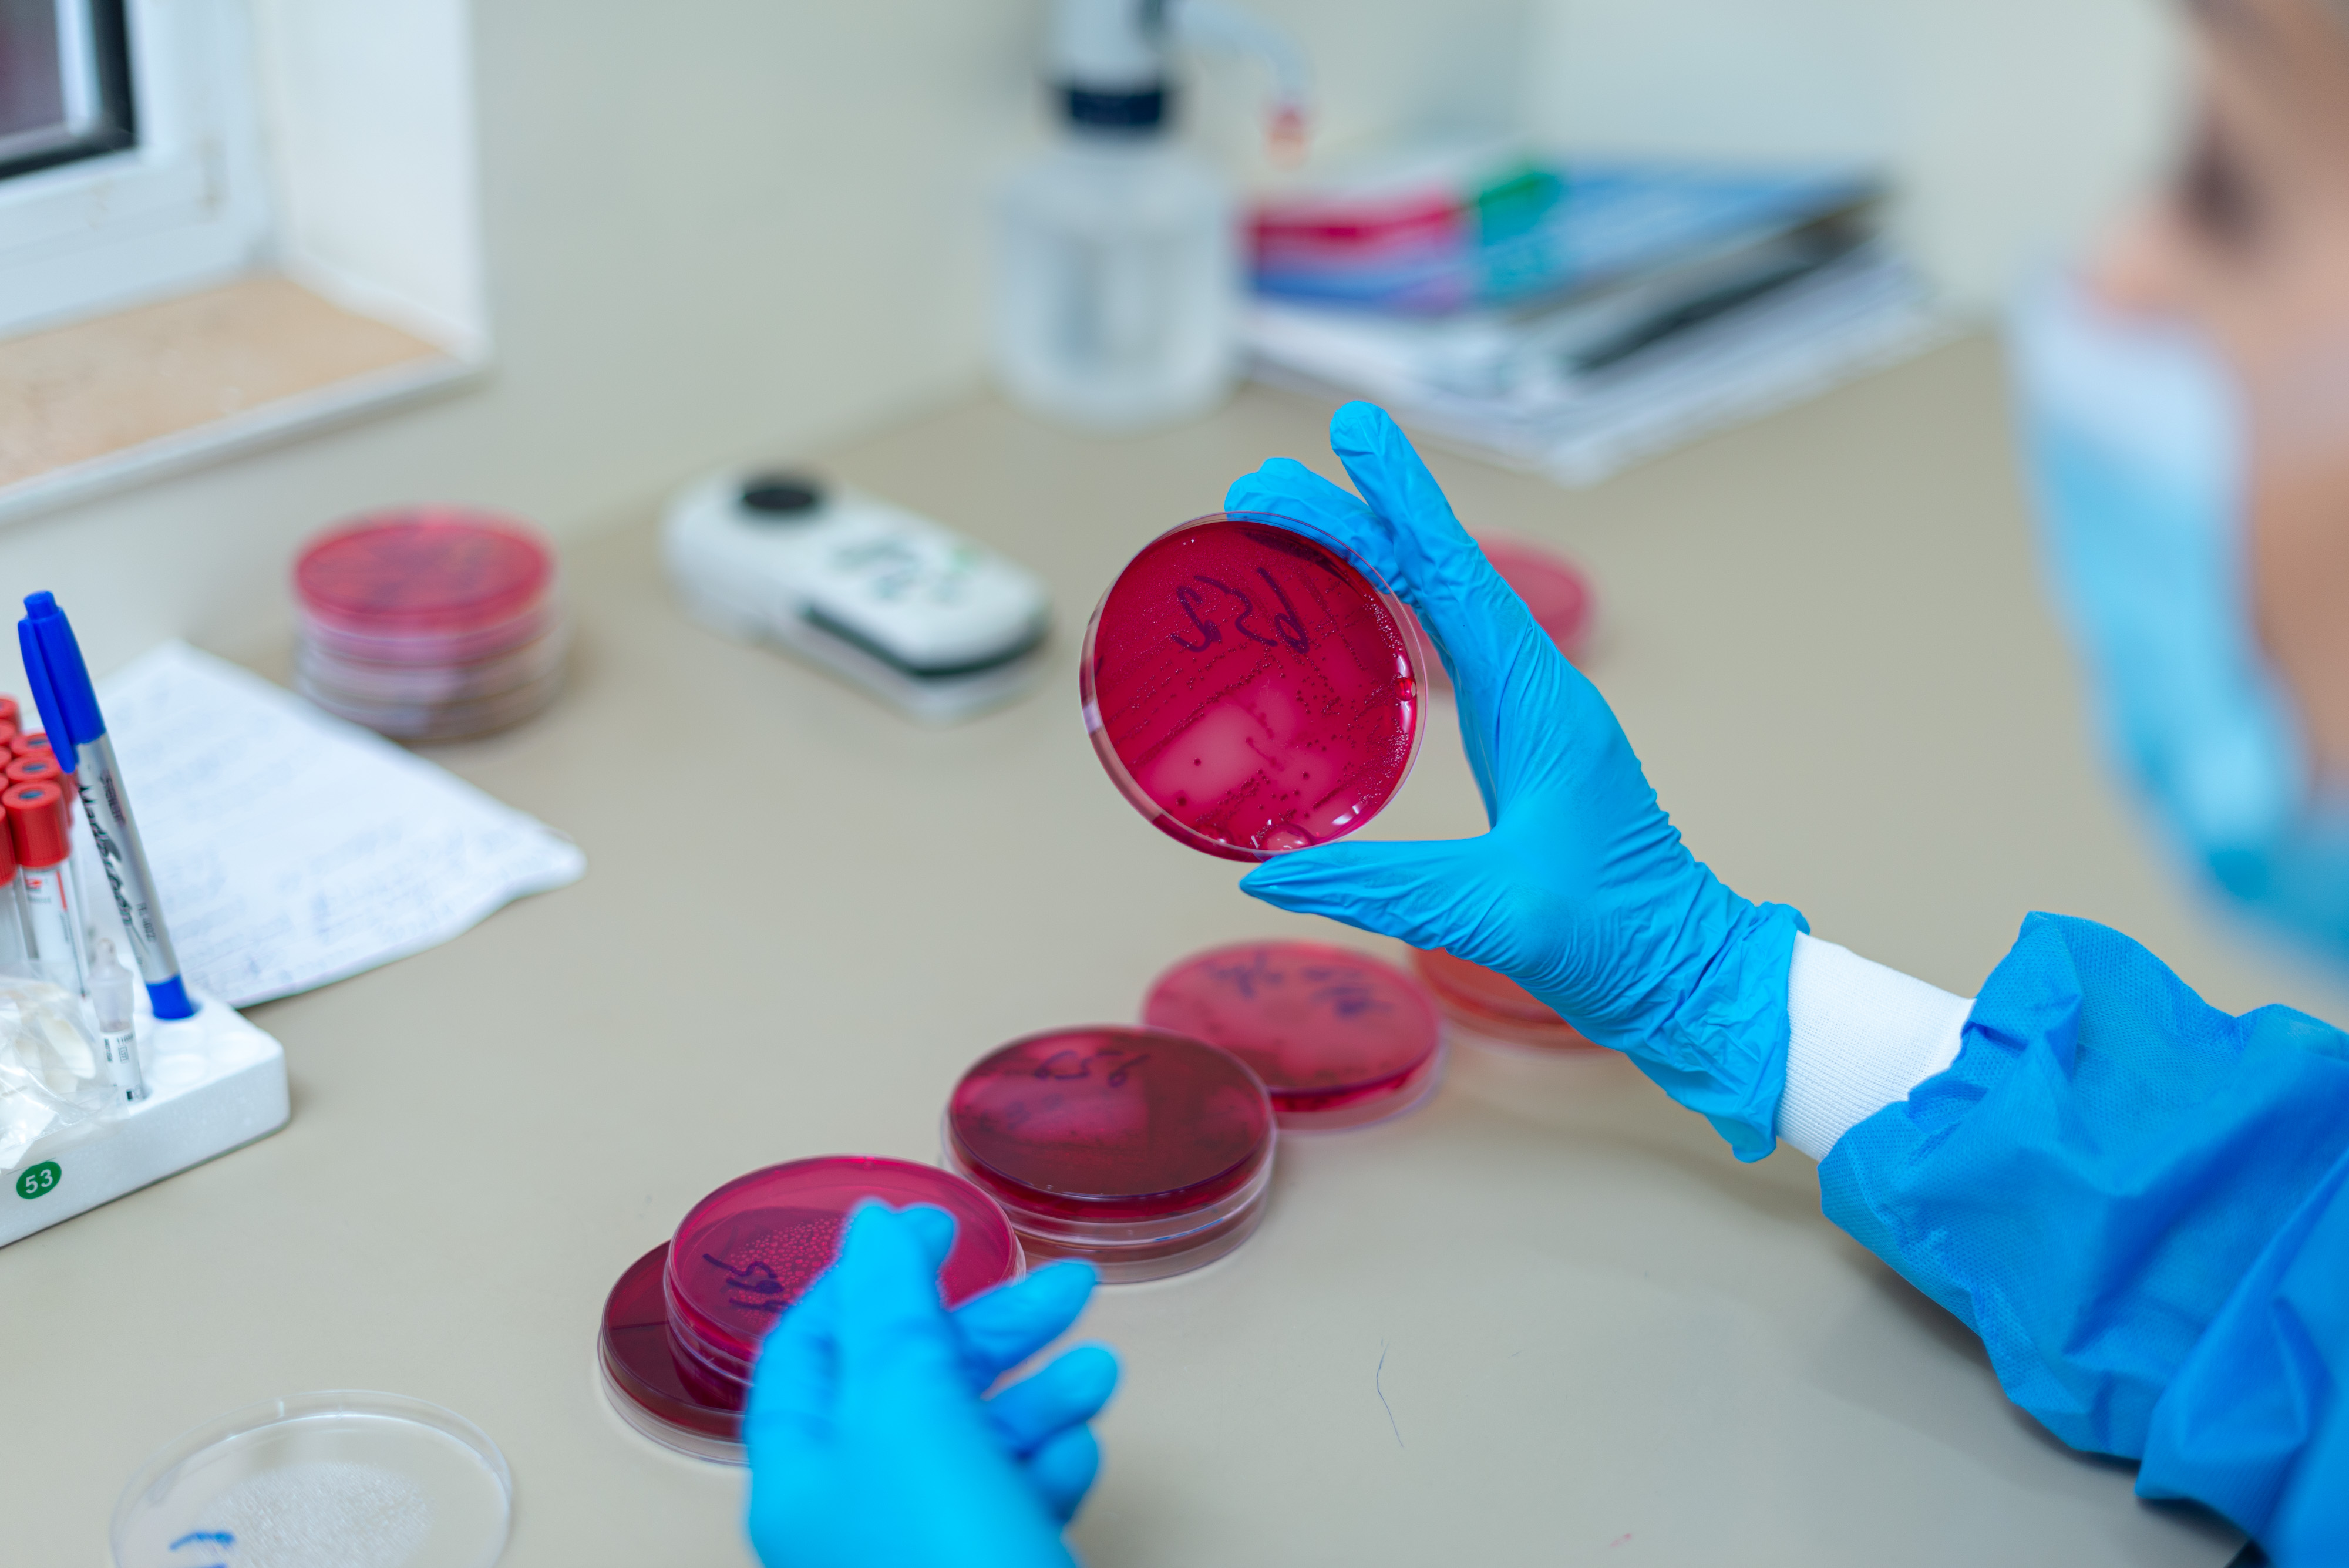

Конференция «Эпилепсия: вне тени» стала реальностью
09 февраль
Сегодня - Международный день эпилепсии.
Это хроническое неврологическое заболевание, проявляющееся повторяющимися приступами. В мире более 60 миллионов человек живут с эпилепсией.
Совместными усилиями Медицинского комплекса «Арабкир» и благотворительного фонда «Дорога жизни» была организована конференция под названием «Эпилепсия: вне тени». Она посвящена важным вопросам здоровья, образования и социальной интеграции детей с эпилепсией. Конференция объединила специалистов отрасли, представителей министерств, педагогов, пациентов и их родителей, журналистов и всех, кого волнует эта проблема.
«С гордостью хочу отметить, что число проведённых вмешательств, в результате которых дети были излечены хирургическим путём, достигло почти 100, - отметил научный руководитель Медицинского комплекса «Арабкир» Ара Баблоян и добавил: - Ребёнок, прооперированный в Казахстане и приехавший в Армению с ежедневными приступами, сегодня их больше не имеет».
Министр здравоохранения Республики Армения Анаит Аванесян подчеркнула: «Мы обеспечиваем медикаментозное лечение для каждого ребёнка, но не будем ограничиваться только этим. Благодаря новым технологическим возможностям мы будем обеспечивать стабильное состояние. Услуга дорогостоящая, но для нас жизнь каждого ребёнка жизненно важна, а его полноценное развитие - бесценно».
Активное участие в конференции также приняли руководитель службы неврологии и эпилептологии Медицинского комплекса «Арабкир» Биайна Сухудян, руководитель благотворительного фонда «Дорога жизни» Елена Багдасарян, директор Республиканского психолого-педагогического центра Министерства образования, науки, культуры и спорта Республики Армения Лилит Мнацаканян, начальник управления охраны здоровья матери и ребёнка Министерства здравоохранения РА Нуне Пашаян и начальник управления лекарственной политики и медицинских технологий Министерства здравоохранения Марине Арутюнян.
В ходе конференции были представлены результаты работы, проделанной в сфере эпилептологии за последние годы, а также современные подходы к лечению. Подобные мероприятия имеют большое значение, поскольку направлены на выявление, обсуждение и во многих случаях решение проблем уязвимых групп общества.
15 апреля отмечено в медицинском календаре как День специалиста лабораторной диагностики.
Лабораторная служба медицинского комплекса “Арабкир” работает ежедневно и круглосуточно, предлагая полный пакет диагностики людям всех возрастов, от новорожденных до совершеннолетних и пожилых людей, независимо от того, является ли человек пациентом, проходящим лечение в медицинском комплексе “Арабкир” или нет.

 Русский
Русский
 Հայերեն
Հայերեն English
English